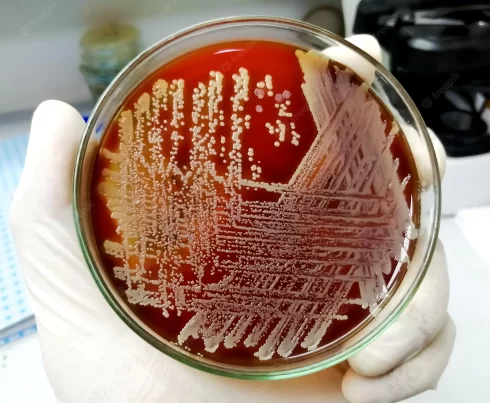
بلاد آگار

آرشیو دسته بندی: ابزار و وسایل آزمایشگاهی شامل، محلول ها کیت ها
مولر هینتون آگار (MHA): ترکیب، اساس، کاربردها و آماده سازی
مقدمهای بر مولر هینتون آگار (MHA) مولر و هینتون در سال ۱۹۴۱ مولر هینتون آگار[بیشتر بخوانید]
بلاد آگار: ترکیب، مراحل آمادهسازی، موارد استفاده
بلاد آگار (Blood Agar (BA)) محیط کشت غنی شدهای است که برای کشت باکتریها یا[بیشتر بخوانید]
10 دیدگاه
کاربرد و مزایا رده سلولی HEK293
کاربرد و مزایا رده سلولی HEK293 سلول های جنینی کلیه 293 (HEK293 ، HEK-293 یا[بیشتر بخوانید]
3 دیدگاه
قیف بوخنر چیست؟
قیف بوخنر قطعه ای از تجهیزات آزمایشگاهی است که در فیلتراسیون استفاده می شود. به[بیشتر بخوانید]
2 دیدگاه
کاغذ صافی چیست؟
کاغذ فیلتر یک سد کاغذ نیمه تراوا است که عمود بر جریان مایع یا هوا[بیشتر بخوانید]
ظروف آزمایشگاهی
ظروف آزمایشگاهی ظروف شیشه ای آزمایشگاهی به تجهیزات مختلفی گفته می شود که در کارهای[بیشتر بخوانید]
قفس نگهداری حیوانات آزمایشگاهی
حیوانات آزمایشگاهی در ظروف مخصوصی نگهداری می شوند. این ظروف ساختار ویژهای دارند که شرایط[بیشتر بخوانید]
12 دیدگاه
مقید کننده موش آزمایشگاهی
مهار کردن حیوانات آزمایشگاهی همیشه یکی از معضلات محققان بوده است. برای اینکه یک حیوان[بیشتر بخوانید]
2 دیدگاه
رک موش آزمایشگاهی
حیوانات آزمایشگاهی در قفس های مخصوص خود نگهداری می شوند. قفس ها نیز در رک[بیشتر بخوانید]
2 دیدگاه
راهنمای خرید فلاسک کشت سلولی: انواع و کاربردها
فلاسک کشت سلولی چیست؟ فلاسک کشت سلولی نوعی ظرف آزمایشگاهی است که به طور ویژه[بیشتر بخوانید]
2 دیدگاه
تجهیزات آزمایشگاه کشت میکروبی
تجهیزات آزمایشگاه کشت میکروبی آزمایشگاه های میکروبیولوژی، عموماً یکسری ابزار و وسایل عمومی و مشترک[بیشتر بخوانید]
سمپلر چیست؟
آزمایشگاه ژنیران دارای انواع سمپلر های Socorex و brand میباشد. سمپلر: سمپلر یکی از[بیشتر بخوانید]
2 دیدگاه